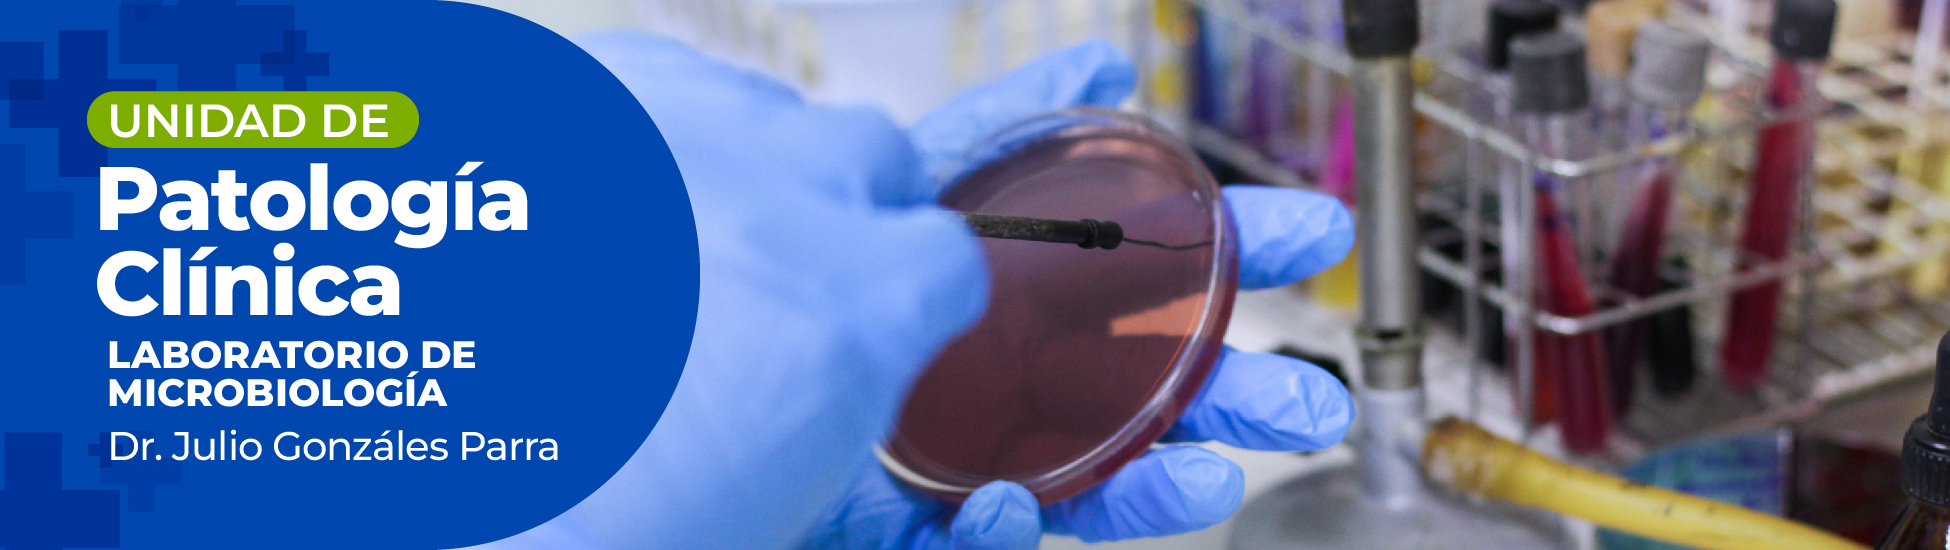

La Unidad de Patología Clínica tiene como objetivo prioritario prestar servicios confiables, oportunos y de calidad en el área de la Microbiología Humana y Veterinaria
- Coloraciones y estudios directos.
- Exámenes en fresco
- Fresco + KOH
- Coloración de Gram
- Coloración de Ziehl-Neelsen y Kinyoun
- Cultivos Microbiológicos para investigar Bacterias, Hongos (Superficiales y Profundos) y Mycobacterias (BK) en: Líquidos Orgánicos (LCR-Liquido pleural-liquido peritoneal-Liquido articular etc.)
- Secreciones en general (Respiratorias, ulceras, heridas etc.)
- Tejidos orgánicos (Ganglios-tejido pleural etc.)
- Exudados (faríngeo-nasal etc.)
- Urocultivos
- Coprocultivos
- Hemocultivos
- Espermocultivos
- Estudios especiales: Secreciones vaginales, uretrales, prostáticas (Test de Stamey)
- Serología de hongos (micosis profundas)
Contacto
- Av. Las Delicias, Urb. El Bosque, Edif. Centro Médico Maracay, Torre C, Piso 2 del Centro Médico Maracay
Lunes a viernes de 8:00 a 12:00 m y de 1:00 pm a 5:00 pm y los sábados de 9:30 am a 11:00 am
- Telf.: 0243 - 200 3700 Ext. 2850
- Directo: 0243 - 232 1821
- Cel: 0412 - 457 1254
- upaclica2@yahoo.es.upaclica2@yahoo.es.

